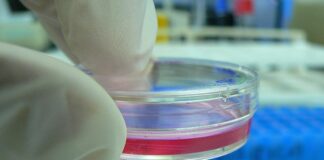
Ciencia y Tecnología Utilizan microondas y ensayan una terapia localizada para atacar tumores Ensayo de laboratorio con una técnica para eliminar tumores

Etiqueta: Microondas
Ciencia y Tecnología Utilizan microondas y ensayan una terapia localizada para...
Un muy buen resultado arrojó la simulación y ensayo de laboratorio, con el que se pretende avanzar en una terapia para tratar tumores de...